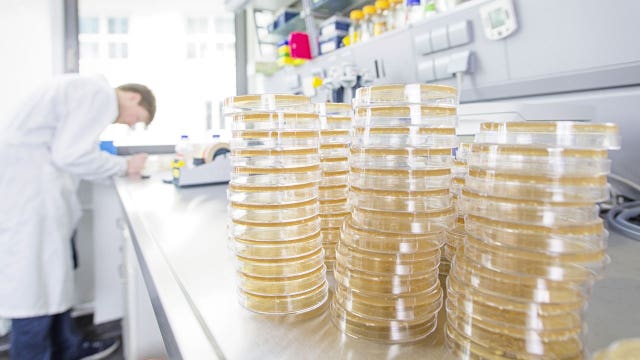
Preservative found in processed foods may be linked to autism, researchers suggest

'Look at me!': 4-year-old with rare disorder excited to walk at physical therapy
This touching video of an enthusiastic little boy at physical therapy will melt your heart.
This touching video of an enthusiastic little boy at physical therapy will melt your heart.
Visitor finds decapitated sea lions on California beach, discovery not as sinister as she thought
Katie Harrison was taking a weekend walk along Mussel Rock Park Beach in Daly City when the sight of decapitated sea lions and a man walking around with a hunting knife sent her into "a state of terror."
Katie Harrison was taking a weekend walk along Mussel Rock Park Beach in Daly City when the sight of decapitated sea lions and a man walking around with a hunting knife sent her into "a state of terror."
Report: FTC approves roughly $5B fine for Facebook
The FTC has voted to approve a fine of about $5 billion for Facebook over privacy violations, the Wall Street Journal reported Friday. The report cited an unnamed person familiar with the matter.
The FTC has voted to approve a fine of about $5 billion for Facebook over privacy violations, the Wall Street Journal reported Friday. The report cited an unnamed person familiar with the matter.
Former NFL player now a sculptor in Georgia
Stone Mountain-based artist George Nock does a little bit of everything. Paintings hang on the wall, but sculpture is his go-to lately. His current project is a commission by a group in Orlando, commemorating the first ever racially integrated Little League baseball game in the area.
Stone Mountain-based artist George Nock does a little bit of everything. Paintings hang on the wall, but sculpture is his go-to lately. His current project is a commission by a group in Orlando, commemorating the first ever racially integrated Little League baseball game in the area.
30 types of CVS Health brand eye drops recalled due to sterility concerns
Altaire Pharmaceuticals, Inc., has issued a voluntary recall for 30 different types of CVS Health brand over-the-counter eye drops due to concerns about sterility of the products.
Altaire Pharmaceuticals, Inc., has issued a voluntary recall for 30 different types of CVS Health brand over-the-counter eye drops due to concerns about sterility of the products.
Preservative found in processed foods may be linked to autism, researchers suggest
A recent study found that there may be a link between a chemical in processed foods and autism.
A recent study found that there may be a link between a chemical in processed foods and autism.
Boy suffering from genetic disorder asks people to ‘bless' police officers with cards on birthday
A selfless 15-year-old Pennsylvania boy who suffers from Krabbes disease is asking for people to “bless” police officers with cards for his birthday on Saturday.
A selfless 15-year-old Pennsylvania boy who suffers from Krabbes disease is asking for people to “bless” police officers with cards for his birthday on Saturday.
Twitter gradually comes back online after hour-long outage
Twitter experienced widespread outages Thursday on both mobile and web platforms.
Twitter experienced widespread outages Thursday on both mobile and web platforms.
Disney reportedly refuses to allow Spider-Man engraving on tombstone of dead boy who loved superhero
A grieving father who lost his 4-year-old son last year claims Disney is not allowing him to include an etching of Spider-Man on the boy's tombstone — citing company policy.
A grieving father who lost his 4-year-old son last year claims Disney is not allowing him to include an etching of Spider-Man on the boy's tombstone — citing company policy.
Couple receives backlash for hosting MAGA-themed wedding
A Michigan couple is facing a mix of praise and pushback on social media for hosting a wedding themed after President Donald Trump's 2016 campaign slogan 'Make American Great Again.'
A Michigan couple is facing a mix of praise and pushback on social media for hosting a wedding themed after President Donald Trump's 2016 campaign slogan 'Make American Great Again.'
Armed pastor holds Tampa church burglary suspect at gunpoint until police arrived
A burglary suspect picked the wrong church to break into.
A burglary suspect picked the wrong church to break into.
Many who have died of cardiac arrest may have had undetected heart attacks, study says
A team of researchers set out to determine the prevalence of silent heart attacks in individuals that had suffered sudden cardiac death and found a substantial link between the two.
A team of researchers set out to determine the prevalence of silent heart attacks in individuals that had suffered sudden cardiac death and found a substantial link between the two.
Eat more hummus: Chickpeas used in popular snack are good for Earth's soil, report says
An ingredient in hummus has been found to be good for Earth’s soil, a report said Wednesday.
An ingredient in hummus has been found to be good for Earth’s soil, a report said Wednesday.
Illinois cancels band from fair lineup over Confederate flag
Country rock band Confederate Railroad has been barred from performing at an Illinois state fair because of its use of the Confederate flag, setting off a firestorm by southern Illinois fans who believe they're under Chicago liberals' thumb of political correctness.
Country rock band Confederate Railroad has been barred from performing at an Illinois state fair because of its use of the Confederate flag, setting off a firestorm by southern Illinois fans who believe they're under Chicago liberals' thumb of political correctness.
Teen recruited as model after being turned down for summer job at Six Flags because of hairstyle
Kerion Washington, 17, was turned down for a summer job at Six Flags Over Texas because of his dreadlocks, but now the teen is pursuing a modeling career.
Kerion Washington, 17, was turned down for a summer job at Six Flags Over Texas because of his dreadlocks, but now the teen is pursuing a modeling career.
Hooters expanding family-friendly restaurant ‘Hoots' without revealing uniforms
Hooters, the original “breastaurant” of America, is hoping that people really do like the wings. The company is reportedly planning an expansion of its more family-friendly restaurant, Hoots.
Hooters, the original “breastaurant” of America, is hoping that people really do like the wings. The company is reportedly planning an expansion of its more family-friendly restaurant, Hoots.
‘God in his top pocket': Man survives after being swept over Niagara Falls, plunging 188 feet
A Canadian man survived after being swept over the largest waterfall at Niagara Falls on early Tuesday morning.
A Canadian man survived after being swept over the largest waterfall at Niagara Falls on early Tuesday morning.
Florida fast food manager told to 'go back to Mexico' after he spoke to his employee in Spanish
Video of an exchange inside a Eustis Burger King is going viral.
Video of an exchange inside a Eustis Burger King is going viral.
Broken car door or beach scene? Optical illusion sparks social media debate
An optical illusion taking social media by storm is proving that everything you see isn't necessarily what it seems.
An optical illusion taking social media by storm is proving that everything you see isn't necessarily what it seems.
YouTube exec apologizes for calling police on black man despite son's pleas outside apartment
A white man seen in a now-viral video calling the police on a black man waiting for a friend at a San Francisco apartment building said that his father was murdered outside his home by a trespasser and that he reacted based on his past history.
A white man seen in a now-viral video calling the police on a black man waiting for a friend at a San Francisco apartment building said that his father was murdered outside his home by a trespasser and that he reacted based on his past history.